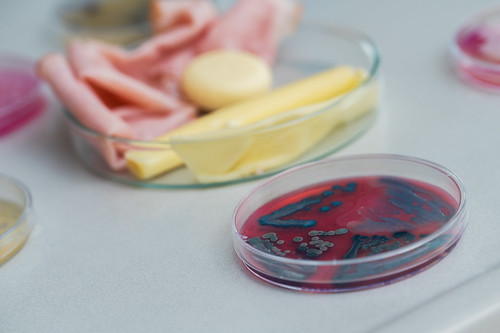

Micro-Tramper
Mikrobielle Dynamiken entlang der Lebensmittelkette
Da Mikroorganismen einen Großteil der Biodiversität unserer Erde ausmachen, sind mikrobielle Ströme allgegenwärtig. Auch in den heutigen Agrarsystemen und in der Lebensmittelproduktion sind sie von großer Bedeutung, da sie einerseits oft für produktspezifische Eigenschaften wie Geruch oder Geschmack wichtig sind, andererseits aber zu Kontaminationen, Verderb oder Ungenießbarkeit führen können.
Im Projekt Micro-Tramper werden in Kooperation mit fünf österreichischen höheren Lehranstalten mikrobielle Ströme entlang der Lebensmittelherstellung untersucht. Das wissenschaftliche Ziel ist die Erforschung des Erbguts relevanter Mikroben in der Lebensmittelproduktion, sowie das Entschlüsseln der Aufgabe bestimmter mikrobieller Gene im Reifungsprozess von fermentierten Lebensmitteln.
Im Projekt beproben Schülerinnen und Schüler landwirtschaftliche Familienbetriebe, die in der Lebensmittelproduktion tätig sind, sie beproben eigens hergestellten Käse zu verschiedenen Reifungszeitpunkten, sie beproben ihre Haushaltsküche und schlussendlich sich selbst. Aus den Proben extrahieren sie mikrobielle DNA und bestimmen über eine Sequenzierung unter wissenschaftlicher Anleitung durch Projektmitarbeiter/innen vor Ort die mikrobielle Zusammensetzung mit einem tragbaren MinION-Sequenzierer. Datenauswertungen werden an den Partnerschulen etabliert und die Mikrobiomdaten werden verglichen und gemeinsam interpretiert.
Anhand der erhobenen Daten können Schülerinnen und Schüler mit den familiären Kleinbetrieben i.) schon etablierte Hygienemaßnahmen evaluieren und Optimierungen diskutieren, ii.) Lebensmittelverlust im eigenen Haushalt überdenken und gemeinsam mit der Familie durch sinnvolle Adjustierungen reduzieren sowie iii.) Desinfektion als Hygienemaßnahme im (Arbeits-)Alltag gezielt einsetzen. Sie erkennen die Bedeutung mikrobieller Diversität und verstehen Herausforderungen, die sich durch mikrobielle Ströme in der Lebensmittelproduktion ergeben.
Kommunikationsworkshops sollen die Jugendlichen bestärken, ihre eigenen Forschungsaktivitäten weiterzugeben und in diversen Veranstaltungen, darunter Online-Micro-Partys und Micro-Flashmobs vorzustellen. Im Rahmen des Projekts wird auch ein gemeinsamer Song über die Wichtigkeit des Erhalts mikrobieller Diversität entstehen.
Der wissenschaftliche Mehrwert dieses Projekts liegt in der Untersuchung bestimmter mikrobieller Gene die für Widerstandsfähigkeit und Toxizität in Betrieben, sowie mikrobieller Interaktion in Reifungsgeschehen essentiell sind.
Aufbauend auf vorhandene Lehrpläne sollen die über das Projekt angeschafften MinION-Sequenzierer die Möglichkeiten der Schulen, praxisnahe Forschung mit in die Lehre einzubeziehen, nachhaltig erweitern. Lehrkräfte der Partnerschulen werden auf die autonome Nutzung des MinION-Sequenzierers (Oxford Nanopore Technologies) im Unterricht vorbereitet und die Sequenzierer bleiben auch nach Projektende zur eigenständigen Verwendung im Unterricht an den Schulen. Die Partnerschulen vernetzen sich und stehen über die Projektlaufzeit hinaus in Austausch.
Dieses Projekt ist bereits abgeschlossen.
Projektwebsites
Pressespiegel
-
Keimschleuder Kühlschrank (Öffnet in neuem Fenster)2026-04-30, Kurier
-
Was lebt in den Fächern eines Kühlschranks? (Öffnet in neuem Fenster)2026-02-28, Die Presse
-
Keime in der Küche (Öffnet in neuem Fenster)2026-02-27, Der Spiegel
-
Das lauert in Wiener Kühlschränken (Öffnet in neuem Fenster)2026-02-26, vol.at
-
Reichhaltiges Innenleben in Wiener Kühlschränken (Öffnet in neuem Fenster)2026-02-26, Puls24
-
Tausende Bakterienarten bevölkern unsere Kühlschränke (Öffnet in neuem Fenster)2026-02-26, backnanger kreiszeitung online
-
Tausende Bakterienarten bevölkern unsere Kühlschränke (Öffnet in neuem Fenster)2026-02-26, Vaihinger Kreiszeitung
-
Wiener Kühlschränke von Pilzen und Bakterien besiedelt (Öffnet in neuem Fenster)2026-02-26, Die Presse
-
Kühlschrank: Welche Krankheitserreger verbreiten sich und was hilft dagegen? (Öffnet in neuem Fenster)2026-02-26, Deutschlandfunk
-
Haushalt als blinder Fleck der Lebensmittelsicherheit (Öffnet in neuem Fenster)2026-02-25, idw Nachrichten
-
Kühlschränke: Pilze & Bakterien- Wir sollten mehr putzen (Öffnet in neuem Fenster)2026-02-25, Kronehit
-
Tausende Krankheitserreger im Kühlschrank: Putzen wichtiger als Kälte (Öffnet in neuem Fenster)2026-02-25, Der Standard
-
Wiener Kühlschränke stark verunreinigt (Öffnet in neuem Fenster)2026-02-25, Wien.orf.at
-
Sendehinweis TV- Kühlschränke (Öffnet in neuem Fenster)2026-02-25, W24
-
Mikrobiologie von Fleisch und pflanzlichen Alternativen (Öffnet in neuem Fenster)2025-08-11, APA Science Agentur
-
Sustainability of plant-based meat alternatives (Öffnet in neuem Fenster)2025-01-06, PNAS Science Sessions
-
Bakterien gehören zum Essen dazu (Öffnet in neuem Fenster)2023-01-29, Die Presse - Junge Forschung
-
Domestizierung schuf Mikrobenzwillinge im Kuhmagen (Öffnet in neuem Fenster)2023-01-20, Der Standard
-
„Sparkling Science 2.0“ – Förderung für Vetmeduni-Forschungsprojekt (Öffnet in neuem Fenster)2022-10-05, Austria Presse Agentur
-
Sparkling Science Projekt „Micro-Tramper“ (Öffnet in neuem Fenster)2022-10-01, ScienceSlam
Publikation
-
Strachan C: Microbial Population Genomics and Metabolic Trade-offs in the Rumen Microbiome (Öffnet in neuem Fenster)2026-05-28, Veterinärmedizinische Universität Wien
-
2026-05-28
-
2026-05-28
-
2026-05-28
-
2026-05-28
-
2026-05-28
-
2026-05-28
-
2026-05-28
-
2026-05-28
-
2026-05-28
-
Selberherr E: Micro-Tramper- mikrobielle Dynamiken entlang der Lebensmittelkette: Ein Citizen-Science-Projekt für den Biologieunterricht (Öffnet in neuem Fenster)2026-05-28, 25. Internationale Tagung der Fachsektion Didaktik der Biologie (FDdB) im VBIO in Kooperation mit dem Verein Österreichischer Biologiedidaktik (VÖBD) Innsbruck
-
Selberherr E: Micro-Tramper: Mikrobielle Dynamiken entlang der Lebensmittelkette (Öffnet in neuem Fenster)2026-05-28, Österreichische Citizen Science Konferenz 2026 Leoben
-
Selberherr E: Microbiome Research: A Paradigm Shift (Öffnet in neuem Fenster)2026-05-28, 16th Quality Austria Food Forum in Vienna Vienna
-
Selberherr E: Microbiome Research in Food Systems in the Context of One Health (Öffnet in neuem Fenster)2026-05-28, Annual Meeting of the Austrian Society for Hygiene, Microbiology and Preventive Medicine (ÖGHMP) Wien
-
Hartmann M, Strachan C, Thalguter S, Dzieciol M, Weingartner B, Selberherr E: Micro-Tramper: Mikrobielle Dynamiken entlang der Lebensmittelkette (Öffnet in neuem Fenster)2026-05-28, ÖGHMP – Hygiene trifft Mikrobiologie; Wien
-
Hartmann M, Strachan C, Weingartner B, Selberherr E: Micro-Tramper Sparkling Science Projekt (Öffnet in neuem Fenster)2023-10-23, Innovationsdialog 2023: Bildungsmesse Wien
-
Selberherr E: Das Mikrobiom von Lebensmittel (Öffnet in neuem Fenster)2023-10-23, Hygiene trifft Mikrobiologie, ÖGHMP Wien
-
Selberherr E: Keynote lecture on one health concepts in food science: Microbiome research as a connecting force. (Öffnet in neuem Fenster)2023-10-23, 5th Congress of Baltic Microbiologists Vilnius, Lithuania
-
Olmo, R; Wetzels, SU; Berg, G; Cocolin, L; Hartmann, M; Hugas, M; Kostic, T; Rattei, T; Ruthsatz, M; Rybakova, D; Sessitsch, A; Shortt, C; Timmis, K; Selberherr, E; Wagner, M: Food systems microbiome-related educational needs (Öffnet in neuem Fenster)2023-09-25, Microbial BiotechnologyVolume16, Issue7
Unterrichtsmaterial
 Beteiligte Schulen
Beteiligte Schulen
 Partner aus Wirtschaft und Gesellschaft
Partner aus Wirtschaft und Gesellschaft
 Wissenschaftliche Einrichtungen
Wissenschaftliche Einrichtungen